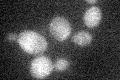
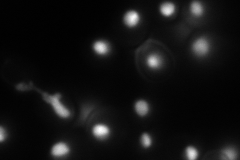
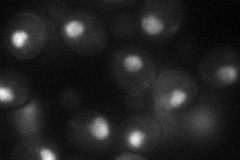
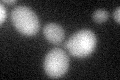

View description
Histone H4, core histone protein required for chromatin assembly and chromosome function; one of two identical histone proteins (see also HHF2); contributes to telomeric silencing; N-terminal domain involved in maintaining genomic integrity
Localization:
Intensity:
Fold change:
Significance:
-
C’ GFP library in SD
below threshold17.81 -
N' NOP1pr-GFP in SD
nucleolus149.072 -
N' TEF2pr-mCherry in SD

nucleolus17.6035 -
N' NATIVEpr-GFP in SD

nucleus45.2145 -
N' TEF2pr-VC and Cyto-VN in SD
nucleus46.0028 -
C’ GFP library in SD+DTT
cytosol16.30.91No -
C’ GFP library in SD+H2O2

cytosol15.920.89No -
C’ GFP library in Starvation Media

cytosol17.420.97No -
C’ GFP library on the background of Pup2-DaMP

below threshold -
C’ GFP library on the background of CCT mutant

below threshold15.26270.856585No
